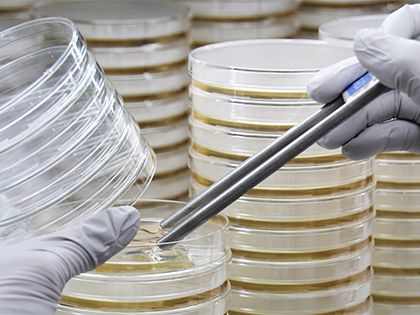
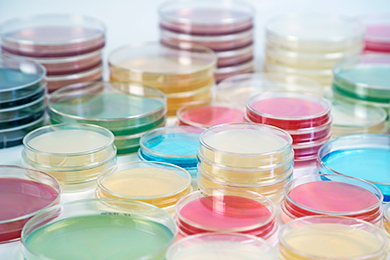
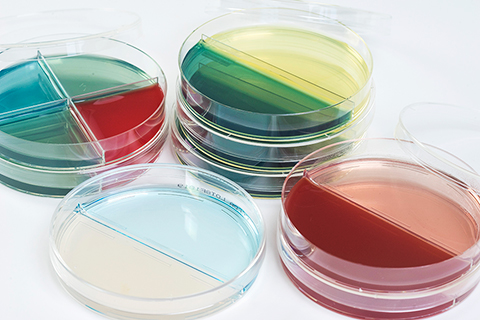
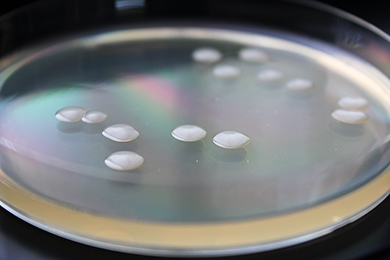

製品紹介
- 私たちの製品は、様々な分野で活用されています。
無菌充填を
ご要望のお客様
平板培地

平板自動充填機の稼働動画を見る 44秒
- 平板自動充填機では、毎時1,500枚の製造が可能です。
- 小スケール製造は手動充填により対応します。最低100枚から受注いたします。
平板培地
直径90mmのシャーレ(JIS K0950-1988準拠)へ、単一の寒天培地を無菌充填した製品です。
一般的に広く使われている90mmシャーレのほか、60mシャーレへの充填も可能です。また、どんなメーカーのシャーレへの無菌充填も承ります。
- <製品例>
-
- 【臨床検査用】 ヒツジ血液寒天培地、ウマ血液寒天培地、チョコレート寒天培地、ミューラーヒントン寒天培地
- 【食品検査用】 標準寒天培地、デソキシコレート寒天培地、卵黄加マンニット食塩寒天培地
- 【医薬品・化粧品検査用】 ソイビーン・カゼイン・ダイジェスト(SCD)寒天培地、ガンマ線照射滅菌済SCD寒天培地、サブローデキストロース寒天培地、CP加ポテトデキストロース寒天培地
- 【研究用】 マイコプラズマ否定試験用培地
分画培地
隔壁(仕切り)を設けた90mmシャーレに複数の寒天培地を充填した製品です。2分画シャーレはじめ、3分画や4分画シャーレへの充填が可能です。
低仕切りタイプは、2種類の培地に同時に画線塗抹できます。
- <製品例>
-
- ヒツジ血液寒天培地/BTB寒天培地
- ヒツジ血液寒天培地/チョコレート寒天培地、SS/SMAC寒天培地
シャーレ印字


レーザー刻印、またはインクジェットにて、製品名、LOT、有効期限などを印字できます。シャーレ単体での識別が可能となります。
試験管培地


バイアル瓶自動充填機の稼働動画を見る 42秒
- バイアル瓶自動充填機では、毎時1,000本の製造が可能です。
- 特殊な形状や小スケールの場合は手動充填により対応します。最低100本から受注いたします。
鑑別培地

ガラス試験管に培地を充填し、高層または斜面に固めたものです。分離菌の各種鑑別試験に用いられます。
試験管培地の種類に応じ、ネジ口試験管キャップ、またはワンタッチで簡単にフタの開閉ができる2(ツー)ポジションキャップを用いた製品をご用意しております。
- <製品例>
- TSI培地、SIM培地、LIM培地、VP半流動培地
2ポジションキャップ
モルトン栓の取り外しやすさと、スクリューキャップの密封性を兼ね備えた試験管キャップです。キャップ内にリブがあり、試験管を片手でつかんで指でキャップの位置をずらすことによって、通気状態と密閉状態の2つのポジショニングが容易に可能です。
図のような簡単な操作で開閉ができますので、一度に多数の試験管培地に菌体を接種する場合において作業時間の短縮が図れます。
※正確な反応を得るために、培養時には通気状態にしてください。
バイアル瓶、微量容器

プラスチック微量容器、ガラス試験管、バイアル瓶(スラント培地)など、様々な長さ、太さ、材質の試験管容器に無菌充填いたします。
- <製品例>
- カンジダ検査用スラント培地、スキムミルク(菌体保護剤)
スタンプ培地


スタンプ自動充填機の稼働動画を見る 36秒
- スタンプ培地自動充填機では、毎時2,000枚の製造が可能です。
- 各種寒天培地のスタンプ培地化が可能です。
スタンプ培地

培地表面が盛り上がっており、フタを開けて検査対象物に押し付けて使用します。主に食品環境の衛生管理に使用されます。
ガンマ線照射した多重包装品は、クリーンルームの清浄度管理(コンタクトプレート法)に用いられます。
- <製品例>
- 標準寒天培地、SCD寒天培地、ガンマ線滅菌SCD寒天培地
特殊容器への培地充填
- 特殊な形状をした容器については、無菌作業に熟練した作業員が手作業で充填します。
パウチ入り培地

スタンディングパウチに寒天培地を充填した製品です。
食品・医薬品などの混釈培養検査用に、培地の自家調製は不要で、加温溶解するだけで使用できます。
培地性能試験は当社が行いますので、自家調製培地に必要な品質試験を省くことができます。
- <製品例>
- 標準寒天培地、デゾキシコレート寒天培地、SCD寒天培地
ハンド型培地

手指の菌検査用の培地です。手洗い前後に検査し効果確認に用いることにより、食品産業に従事する方々の衛生意識向上に役立ちます。
- <製品例>
- 卵黄加マンニット食塩培地、SCD寒天培地、標準寒天培地
ガンマ線照射培地
- ガンマ線照射した各種の培地製品についても、安定した供給実績があります。
ガンマ線照射済平板培地・スタンプ培地

落下菌、
浮遊菌数測定用
SCD寒天培地
(2重包装および

表面付着菌数測定コンタクトプレート法用
SCDスタンプ培地
(2重包装および
シャーレに無菌充填した培地をフィルム包装した後、包装資材ごとガンマ線を照射し滅菌した製品です。 フィルム包装は、2重または3重に多重包装されています。
シャーレ内部および包装内部についても無菌性が保証されており、医薬品工場等のクリーンルームに持込み使用されます。
ソイビーン・カゼイン・ダイジェスト(SCD)寒天培地や真菌用サブロー・ブドウ糖寒天培地などが用いられます。
- <製品例>
-
- ガンマ線照射済SCD寒天培地(2重包装)
- ガンマ線照射済SCDスタンプ培地(2重包装)
培地充填試験用濃縮培地

バックインボックス入り
10倍濃縮SCD培地(液体培地)
ガンマ線照射による滅菌処理を施したバックインボックス(BIB)入り10倍濃縮液体培地です。滅菌水などで10倍希釈して使用します。
- <製品例>
- 10倍濃度SCD培地(液体培地)
研究機関向け各種培地
医薬品や食品の安全性を検査するための一般的培地のほか、分子生物学分野、バイオ燃料、農業、その他の様々な分野で使用される「培養用培地」製造にかかわる課題解決に取り組みます。
大量培養用濃縮培地の製造なども承りますのでお問い合わせください。
- <製品例>
- 植物、動物細胞培養用、藻類用培地、その他

